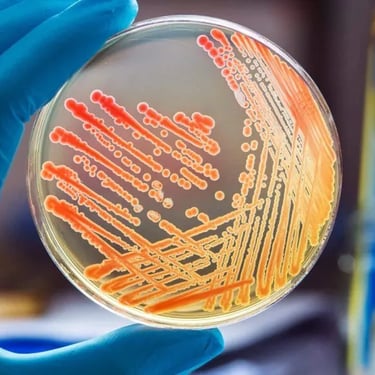

Rated 5 stars
★★★★★
This blog is educational purposes only and is not associated with the brand in any way.
One's Journey
At Google Gemini, we start small by tackling one educational challenge, then watch that solution inspire countless others.


Think Big
Start Small
It's not about memorizing. it's the learning that counts. Gemini finds the best way for one to learn.






Hey Gemini, personalize my syllabus
📚
Tailored to your school, course, and even professors
Hey Gemini. Track my study journey
📖
Report progress, mastery, and weaknesses.
Hey Gemini. Unlock Cerificates
Earn accredited exam certification.
📕
This blog is for educational purposes only and is not associated with the brand in any way.
Bring Ideas to life
Ignite learning by solving one challenge with Gemini’s power.
Deeper Learning


Gemini 3 Deep Think can better help tackle real world problems that require rigor, breakthrough creativity and intelligence.




Ideas Come true
Bring your ideas to life – from sketches and prompts to interactive tools and experiences
Gemini 3 thinks smarter. It can build a seamless 3D journey from a tiny proton to the entire observable universe.
Envision Anything
This blog is for educational purposes only and is not associated with the brand in any way.
Our Breakthroughs
AlphaFold

Our latest AI technology is helping scientists solve the world’s most pressing challenges.
AlphaFold bridged Bioinformatics and Structural Biology in seconds which is a 50-year-old thermodynamic puzzle called Anfinsen’s Dogma
Core Features




Immediate access to a database with over 200M+ data structure
Transform insights into visionary graphics for testing and conformation
Mapping mutations directly into 3D structures to understand how they cause diseases.


The Breakthrough
It has collapsed the "hit-to-lead" phase of drug discovery from years of expensive trial and error into weeks of precise digital modeling, potentially halving the time it takes to get life-saving medicines to patients.
AlphaFold took biology from a game of "guess the shape" to a world where we have the blueprint for every biological machine on Earth.


This blog is for educational purposes only and is not associated with the brand in any way.
This blog is for educational purposes only and is not associated with the brand in any way.
Multimedia Content Illustration
The website is for educational purposes only. It is not associated with the brand in any way.


This bulletin board is designed to showcase Gemini Pro capability of reducing your stress by handling tasks for you. It positions Gemini Pro as not only a large language model, but a life partner helping you.


This Gemini Pro bus shelter board is an ad that aims to create an "in-mirror" experience for its audiences waiting at the shelter. If it’s raining or dark outside while you wait for the bus, the ad feels like a reflection of your current reality.The requests made demonstrate Gemini Pro's abilities in
Real-time data collection
Geographical AI advancement
Visual and contextual awareness and analysis skills
Integrated personal assistant feature
Gemini Pro is more than a large language model.
Gemini Pro is your
Assistant
Teacher
Support system






This Instagram post aims to position Gemini Pro as a handy assistant that is there to solve your issues with you.
This Instagram post aims to demonstrate Gemini’s ability to analyze a photo or video in real-time to give expert advice.
This Instagram post aims to show Gemini Pro's massive information processing system and showcases Its strong ability to teach